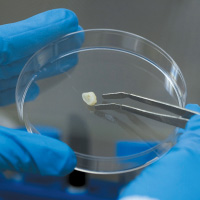
Dental pulp

CT-MSCs and DP-MSCs do show significant differences in more specialised functions. Being aware of the possibilities, potential and limitations, is essential when selecting the most appropriate source of MSCs for treatment.

Dental Pulp

Cord tissue
UC-MSCs can generate adipocyte derivative tissues? at a greater quality while the DP-MSCs can proliferate? faster and generate a larger number of cells for potential therapies and have a greater capacity for cartilage generation and neural cell generation (Cui, Chen et al. 2015, Yang, Chen et al.
In a recent protein expression study it was identified that the set of protein and bioactive factors? is different between the UC-MSCs and DP-MSCs to facilitate for different types of treatments and complement each other (Caseiro, Santos Pedrosa et al. 2019).
In a more in-depth study regarding the gene expression profile, the profiles of Bone Marrow-MSC, Adipocyte Tissue-MSCs and UC-MSCs were similar while DP-MSCS differed in relative gene expression in several functional genes (Stanko, Kaiserova et al. 2014).
Li et al, have found that the UC-MSCs have a higher immunomodulatory? ability that gives them an advantage and are better suited for cellular therapy for immune-related diseases while the DP-MSCs with the higher proliferation capacity as discussed above as well, are more suited for tissue regeneration-related cellular therapies (Li, Xu et al. 2018).
Especially for DP-MSCs, the prolilferation rate demonstrated by more than 60 population doublings which higlights the time window to expand cells for a therapy (Huang, Gronthos et al. 2009). Equally, signs of degeneration or spontaneous differentiation of the DP-MSCs were absent which indicates that those cells cannot cause tumours when used in therapies (Suchánek, Visek et al. 2010).
Key characteristic and advantage of the DP-MSCs is their stronger ability to survive under the microenvironment of oxidative stress?, which can occur during cell therapy treatments (Zhang, Xing et al. 2018)
A key advantage of the DP-MSCs is that they originate from a region in the brain called the neural crest. Neural crest cells play a pivotal role in embryonic development, giving rise to a variety of cell types such as neurons and glia? of the peripheral nervous system, melanocytes? throughout the body, smooth muscle, craniofacial cartilage and bone (LaBonne and Bronner-Fraser 1999, Chalisserry, Nam et al. 2017, Prasad, Charney et al. 2019), subsequently the potential number therapies deriving from DP-MSCs is enormous and can be life-saving for those that have cells available and ready to be used.

![]()
DP-MSCs can be used to repair tooth in-vivo?. In-vivo natural dentin (the inner structure of the tooth structure) regeneration requires the DPSCs to migrate, proliferate and differentiate into a more specialised cell type which then synthesize matrix? to form functional dentin at the damaged sites (Volponi, Pang et al. 2010, Chalisserry, Nam et al. 2017, Itoh, Sasaki et al. 2018). Current focus in research remains the establishment of viable and easily accessible odontogenic cell-sources? such as DP-MSCs that would lead to future bio-tooth engineering achievements (Volponi, Pang et al. 2010, Aurrekoetxea, Garcia-Gallastegui et al. 2015, Angelova Volponi, Zaugg et al. 2018) .

Dental Pulp
Dental Pulp Cord tissue
Cord tissue



